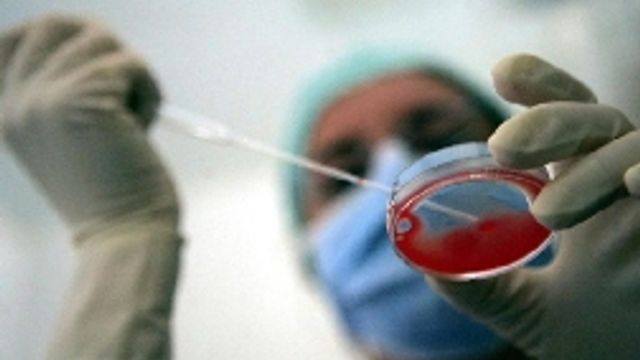

All'ospedale Sant'Anna di Torino è nata la prima bimba d'Italia concepita dopo un autotrapianto di tessuto ovarico. La mamma Rosanna, 29 anni, è la prima donna italiana (e una delle prime al mondo) a portare a termine la gravidanza grazie al trapianto del proprio tessuto ovarico, che era stato prelevato e crioconservato prima di una chemioterapia.
Il risultato è stato possibile grazie all'équipe universitaria della clinica di ginecologiadell'ospedale S.Anna di Torino, diretta da Chiara Benedetto. La neomamma soffriva di beta talassemia dall'età di 21 anni ed era stata sottoposta ad trapianto di midollo osseo e chemioterapia che l'avrebbe resa sterile.
Il prelievo del tessuto ovarico, congelato e conservato in azoto per 8 anni, poi reimpiantato nella donna una volta guarita, le ha permesso di restare incinta. La bimba di chiama Aurora e pesa 3 chili e 670 grammi.